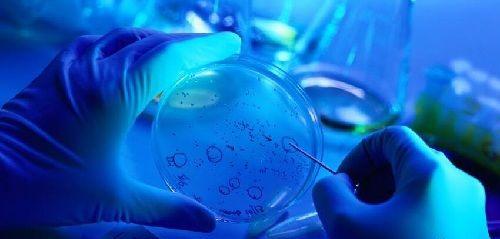
nk细胞免疫治疗法真假：打一针的价格轻松识别骗局

-

nk细胞偏高影响怀孕吗?需要治疗吗?
我和老公在试管阶段,前两天刚取完卵,检查完身体就可以移植了,但是医生说我nk偏高,不适合移植,让我可以先把胚胎冻起来,等身体条件可以了再移植。我想问一下,nk偏高对..
2023-04-08 10:12 -

nk细胞偏高变质副作用会导致胎停
从nk细胞有什么用中可以了解到,nk细胞能治疗癌症和抗衰老,那么是不是说明nk细胞值越高就越好呢?事实并不是这样,特别是针对怀孕妈妈,如果nk细胞偏高,很容易引发胎停、..
2023-10-13 12:11 -

1秒读懂nk细胞轻松了解优势与劣势
说道nk细胞这个词大家肯定很陌生,不过说道自然杀伤细胞可能就熟悉点了,特别是对有过肿瘤病史的患者来讲,肯定接触过nk细胞,不过大家真的了解nk细胞吗?知道nk细胞有哪些..
2023-10-13 12:16 -

nk细胞参考值解读:检查结果32实属正常范围
nk细胞又被称为自然杀伤细胞,和B细胞、吞噬细胞等并列为免疫细胞之一,有着抗癌抗衰老的重要作用,不过nk细胞偏高也会引起女性胎停、流产、试管婴儿移植失败等问题,而nk..
2023-10-13 12:24 -

nk细胞疗法一针多少钱?要打几针?
家里老人得了肿瘤,发现的时候已经是中期了,听说nk细胞免疫疗法是新型的治疗方式,想问一下,我们国家哪里能做啊?nk细胞免疫疗法尚处在研究和临床实验阶段,虽然从理论上..
2023-10-13 12:45 -
nk细胞免疫治疗法真假:打一针的价格轻松识别骗局
免疫疗法全称为肿瘤免疫治疗,在正常情况,人体免疫系统的nk细胞、吞噬细胞、B细胞等能够识别肿瘤细胞,并且对其进行扼杀,而肿瘤细胞为了生长和生存,也会采取不同的策略..
2023-10-13 13:37 -

nk细胞作用:治疗癌症抗衰老两不误
在研究nk细胞过程中,虽然对其具体来源不清楚,但是却知道是从骨髓中衍生的,nk细胞想要发育成熟,就得依赖于骨髓的微环境,通过临床研究,发现nk细胞主要分布于外周血中,..
2023-10-13 14:13
微信分享
扫描二维码分享到微信或朋友圈